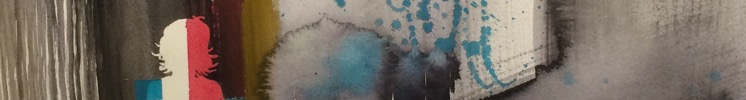

- Håndlaget
- Samler
- Mote
-
Materiell
- Mal & Tegn
- Papir og stempler
- Lage og dekorere
- Smykker og accessoirer
- Sy
- Tekstiler
- Strikke, hekle og tove
- Knapper, bånd og tilbehør
- Pakk inn og gi bort
- Såper
- Hobbyutstyr for barn
- Bøker og Mønster
- Råmaterialer
- Tapetsere og male
- Oppbevaring av verktøy og materiell
- Beslag og elektrisk
- Verktøy og tilbehør
- Utstyr til mat og drikke
- Høytider
Rutheart Brokstad
Velkommen! I epla-butikken Rutheart Brokstad finner du originale akvareller, giclee-trykk og akrylbilder laget av R.T. Brokstad. I epla-butikken finner du mye av det samme som i galleriene, men i tillegg også godbiter du ikke finner andre steder! Godbitene er feks prøvetrykk, originale akryl- og akvarell-bilder, samt kunstkort og collografier. På eplabutikken kan du med andre ord gjøre små og store kupp!
CONNECT:
Lik Facebooksiden på: www.facebook.com/rtbrokstad
Besøk nettsiden: www.rutheart.com.
Møt meg på Instagram: @rutheart
FORHANDLERE:
Fineart (www.fineart.no/kunstner/ruth-therese-brokstad)
Galleri Vesterålen (www.galleri-vesteraalen.no, Sortland, Norge)
Linus Art Gallery (www.linusgallery.com, Los Angeles, USA).
Produkter i kategorien Norwegian landscape
Hei og velkommen! Butikken er midlertidig stengt, men om du vil se på produktene finnes de også på rutheart.com. Velkommen tilbake! Med vennlig hilsen RT :-)
Om Epla
EplaHagen
- Epla er kopibeskyttet © 2026
